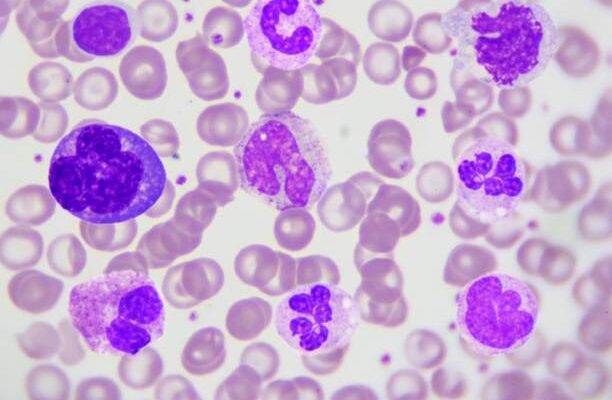
Bazofil düşüklüğü

[box type="shadow" align="alignleft" class="" width=""] Eozinofil yüksekliği nedir? Eozinofil yüksekliği; eozinofillerin dolaşımda gereğinden fazla bulunmasını tanımlayan bir durumdur ve tıp dilinde “eozinofili” olarak adlandırılır. Eozinofil değerlerini yüksek gören doktor, bu kişinin ya alerjen bir durumla ya da bir parazitle mücadele ettiği yargısına varır. Çünkü ancak böyle durumlarda eozinofil saklandığı depolardan.
- 30 Temmuz 2019
- 1
- 420
- 0